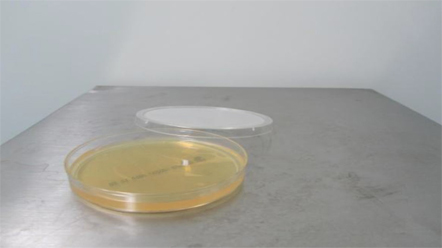
上海環(huán)境檢測(cè)咨詢(xún)服務(wù)有限公司

項(xiàng)目:
(1)溫度與相對(duì)濕度的測(cè)試
(2)換氣次數(shù)的測(cè)試
(3)截面平均風(fēng)速的測(cè)試
(4)氣流流型的測(cè)試
(5)壓差和壓差梯度的測(cè)試
(6)懸浮粒子的測(cè)試
(7)浮游菌的測(cè)試
(8)沉降菌的測(cè)試
(9)照度的測(cè)試
(10)噪聲
(11)高效過(guò)濾器檢漏光度計(jì)法
檢測(cè)方法簡(jiǎn)介
引用標(biāo)準(zhǔn) YBB00412004-2015 藥品包裝材料生產(chǎn)廠房潔凈室(區(qū))的測(cè)試方法
(1)溫度與相對(duì)濕度的測(cè)試
①測(cè)試之前空氣凈化系統(tǒng)應(yīng)至少已連續(xù)運(yùn)行24小時(shí),且系統(tǒng)處于穩(wěn)定和正常運(yùn)行的狀態(tài),測(cè)試人員在采樣時(shí)也應(yīng)注意站在測(cè)試儀器的下風(fēng)側(cè),并應(yīng)盡量少活動(dòng)。
②若局部為恒溫恒濕區(qū)域,則必須在測(cè)試記錄中注明,并按規(guī)定布置采樣點(diǎn)和計(jì)算偏差,采樣點(diǎn)布置如下:若非恒溫恒濕潔凈室(區(qū)),則采樣點(diǎn)為離地0.8m、距墻0.5m的室內(nèi)中心位置;若為恒溫恒濕度潔凈室(區(qū)),則應(yīng)符合以下規(guī)定:
a.每次測(cè)試間隔不大于30分鐘:
b.室內(nèi)采樣點(diǎn)布置應(yīng)包括送回風(fēng)口處、恒溫工作區(qū)具有代表性的地點(diǎn)(例如沿著工藝設(shè)備周?chē)贾没虻染嚯x布置):
c.采樣點(diǎn)一般應(yīng)布置在距墻面大于0.5m,離地面0.8m的同一高度上,也可以根據(jù)恒溫區(qū)的大小,分別布置在離地不同高度的幾個(gè)平面上;
d.采樣點(diǎn)數(shù)應(yīng)符合表1規(guī)定。
表1 溫度與相對(duì)濕度采樣點(diǎn)數(shù)

③采用直接讀數(shù)法,從而評(píng)定該潔凈室(區(qū))的溫度與相對(duì)濕度。若使用電子元件支持的數(shù)字式溫度與相對(duì)濕度計(jì),則儀器開(kāi)機(jī)預(yù)熱至穩(wěn)定后,方可按儀器說(shuō)明書(shū)的規(guī)定對(duì)儀器進(jìn)行校正,并選定相應(yīng)的測(cè)試量程范圍,宜將溫度和相對(duì)濕度計(jì)的測(cè)試探頭盡量與采樣點(diǎn)保持水平面一致,在確認(rèn)讀數(shù)穩(wěn)定后方可開(kāi)始測(cè)試。
④應(yīng)同時(shí)測(cè)試室外的溫度和相對(duì)濕度值。
⑤對(duì)于無(wú)恒溫恒濕要求的潔凈室(區(qū)),溫度與相對(duì)濕度的采樣數(shù)據(jù)與標(biāo)準(zhǔn)對(duì)比后得出合格與否的結(jié)論。對(duì)于有恒溫恒濕要求的潔凈室(區(qū)),判斷溫度與相對(duì)濕度是否符合標(biāo)準(zhǔn)應(yīng)同時(shí)滿(mǎn)足:室溫波動(dòng)范圍與各采樣點(diǎn)的各次溫度測(cè)試數(shù)據(jù)中偏差控制點(diǎn)溫度的最大值一致,占采樣點(diǎn)總數(shù)的百分比整理成累積統(tǒng)計(jì)曲線,若90%以上的采樣點(diǎn)的偏差值在室溫波動(dòng)范圍內(nèi),則為符合規(guī)定,反之則不合格,相對(duì)濕度的波動(dòng)范圍可按室溫波動(dòng)范圍的規(guī)定執(zhí)行。
⑥若同時(shí)測(cè)試兩個(gè)項(xiàng)目以上時(shí),溫度和相對(duì)濕度的測(cè)試宜在最先進(jìn)行,有利于綜合評(píng)估溫度與相對(duì)濕度對(duì)其他項(xiàng)目的影響:太低的相對(duì)濕度會(huì)導(dǎo)致靜電問(wèn)題,使灰塵吸附在金屬表面,而相對(duì)濕度過(guò)高時(shí),微生物污染的風(fēng)險(xiǎn)顯著增大:對(duì)于潔凈室(區(qū))的加濕處理,應(yīng)使用高質(zhì)量的水以避免污染。

(2)換氣次數(shù)的測(cè)試
①對(duì)于非單向流潔凈室(區(qū)),對(duì)每個(gè)送風(fēng)口測(cè)試送風(fēng)量來(lái)?yè)Q算出換氣次數(shù)。
②采用空氣平衡熱輻射測(cè)量?jī)x或風(fēng)量罩,直接讀出每個(gè)送風(fēng)口的送風(fēng)量值(m2/m),潔凈室(區(qū))內(nèi)所有送風(fēng)口的送風(fēng)量之和即為潔凈室(區(qū))送風(fēng)量。
③對(duì)于非單向流潔凈室(區(qū)),也可采用風(fēng)口法或風(fēng)管法確定送風(fēng)量,方法如下。
a.風(fēng)口法是在安裝有高效過(guò)濾器的送風(fēng)口處,根據(jù)送風(fēng)口形狀連接輔助風(fēng)管進(jìn)行測(cè)量。即用鍍鋅鋼板或其他不產(chǎn)塵材料做成與風(fēng)口形狀及內(nèi)截面相同,長(zhǎng)度等于2倍風(fēng)口長(zhǎng)邊長(zhǎng)的直管段,連接于風(fēng)口外部,在輔助風(fēng)管的出口平面上,按最小采樣點(diǎn)數(shù)不小于6點(diǎn)均勻布置采樣點(diǎn),用風(fēng)速儀測(cè)定各采樣點(diǎn)風(fēng)樣點(diǎn)范圍為送風(fēng)口邊界內(nèi)0.05m以?xún)?nèi)的面積,以所有采樣點(diǎn)風(fēng)速讀數(shù)的算術(shù)平均值作為平均風(fēng)速:然后以送風(fēng)口截面平均風(fēng)速乘以送風(fēng)口凈截面積求取風(fēng)量。
b.對(duì)于風(fēng)口上風(fēng)側(cè)有較長(zhǎng)的矩形支管段,且已經(jīng)或可以鉆孔時(shí),可以用風(fēng)管法確定風(fēng)量。測(cè)量斷面應(yīng)位于大于或等于局部阻力部件前3倍管徑或管徑長(zhǎng)邊長(zhǎng)的部位,也可以是局部阻力部件后5倍管徑或管徑長(zhǎng)邊長(zhǎng)的部位,對(duì)于圓形風(fēng)管,應(yīng)根據(jù)管徑大小將截面劃分成若干個(gè)面積相同的同心圓環(huán),每個(gè)圓環(huán)設(shè)4個(gè)采樣點(diǎn),圓環(huán)數(shù)量宜不少于3個(gè),以所有采樣點(diǎn)風(fēng)速讀數(shù)的算術(shù)平均值作為平均風(fēng)速,對(duì)于矩形風(fēng)管,可將風(fēng)管截面劃分成若干個(gè)相等的小截面,每個(gè)小截面盡可能接近正方形,邊長(zhǎng)最好不大于200mm,以每個(gè)正方形的中心點(diǎn)作為采樣點(diǎn)測(cè)試風(fēng)速值,但整個(gè)截面上的采樣點(diǎn)數(shù)不少于3個(gè),以所有采樣點(diǎn)風(fēng)速讀數(shù)的算術(shù)平均值作為平均風(fēng)速;然后,以送風(fēng)口截面平均風(fēng)速乘以送風(fēng)口凈截面積求取送風(fēng)量。

(3)截面平均風(fēng)速的測(cè)試
采用風(fēng)速計(jì)直接測(cè)試。風(fēng)速為0.36~0.54m/s(指導(dǎo)值)。
①對(duì)于垂直單向流潔凈室,測(cè)試時(shí)取離高效過(guò)濾器0.3m垂直于氣流處的截面作為采樣截面,對(duì)于水平單向流潔凈室,測(cè)試時(shí)采樣點(diǎn)應(yīng)取在距送風(fēng)面0.5m的垂直截面上,截面上的采樣點(diǎn)間距不宜大于0.6m,均勻布點(diǎn);采樣點(diǎn)數(shù)應(yīng)不少于5個(gè)。
②測(cè)試風(fēng)速時(shí),宜用測(cè)定架固定風(fēng)速儀,以避免人體干擾;若不得不用手持風(fēng)速儀測(cè)試時(shí),手臂應(yīng)伸至最長(zhǎng)位置,盡量使人體遠(yuǎn)離采樣點(diǎn);在具體操作時(shí)要注意的是,測(cè)試截面風(fēng)速時(shí)測(cè)試儀器的測(cè)試元件前后不能有遮擋物,否則就會(huì)導(dǎo)致數(shù)據(jù)失準(zhǔn)或者無(wú)法測(cè)出風(fēng)速。
③以所有測(cè)點(diǎn)的風(fēng)速讀數(shù)的算術(shù)平均值作為截面平均風(fēng)速,并以截面平均風(fēng)速的數(shù)值與標(biāo)準(zhǔn)對(duì)比得出合格與否的結(jié)論。截面平均風(fēng)速了按本標(biāo)準(zhǔn)“測(cè)試方法”項(xiàng)下第(2)項(xiàng)“換氣次數(shù)的測(cè)試”中的“截面平均風(fēng)速”進(jìn)行。

(4)氣流流型檢測(cè)
本項(xiàng)測(cè)試的目的是確認(rèn)A級(jí)或B級(jí)區(qū)域的氣流流型和潔凈室與相鄰區(qū)域的氣流方向。方法按照ISO14644.3《Cleanrooms and associated controlled environments-Part 3 Test Methods》中4.2.5條款A(yù)irflow direction test and visualization中測(cè)試程序B7進(jìn)行。
對(duì)于A級(jí)或B級(jí)區(qū)域的氣流流型測(cè)試,采用MSP-2010氣流可視化測(cè)試儀測(cè)試。將MSP-2010氣流可視化測(cè)試僅注滿(mǎn)注射用水,調(diào)節(jié)格放蒸汽流量到4升/分鐘并達(dá)到穩(wěn)定,將柱型蒸汽流放置于層流跟LAF下緩慢水平移動(dòng),觀察柱型蒸汽流的流動(dòng)方向,用數(shù)碼影像記錄并文件化,同時(shí)確認(rèn)氣流流型是否符合接受標(biāo)準(zhǔn);對(duì)于潔凈室與相鄰區(qū)域的氣流方向測(cè)試,采用氣流方向測(cè)試棒,在潔凈室與相鄰區(qū)域的縫隙處釋放煙霧,用數(shù)碼影像記錄并文件化,同時(shí)確認(rèn)是否符合接受標(biāo)準(zhǔn)。

(5)壓差和壓差梯度的測(cè)試
本標(biāo)準(zhǔn)定義的壓差值為被測(cè)潔凈室(區(qū))與相鄰區(qū)域或相鄰室外大氣的氣體壓力差。
壓差測(cè)試應(yīng)在風(fēng)量平衡調(diào)節(jié)完畢后進(jìn)行。為了測(cè)量相鄰區(qū)域的壓差,在整個(gè)測(cè)試過(guò)程中用微壓差計(jì)進(jìn)行測(cè)量。測(cè)量時(shí)必須把所有門(mén)全部關(guān)緊,然后從潔凈室的最里面逐步向外測(cè)量,每一個(gè)房間相對(duì)于所有其他房間或區(qū)域的壓差均應(yīng)測(cè)量,在測(cè)量時(shí)應(yīng)特別注意每一個(gè)測(cè)點(diǎn)與其相鄰位置壓差的方向,同時(shí)在氣流流向圖上標(biāo)明壓差梯度。
如果相鄰兩個(gè)房間或區(qū)域之間的壓差有接受標(biāo)準(zhǔn),則用具體數(shù)值表示,無(wú)壓差要求則用“/”表示:“+”則表示“房間”的壓力高于“相對(duì)位置”的區(qū)域;“一”則表示“房間”的壓力低于“相對(duì)位置”的區(qū)域。測(cè)試時(shí)應(yīng)盡量遠(yuǎn)離送風(fēng)口和回風(fēng)口或其他可以影響壓差測(cè)量的因素。有不可關(guān)閉的開(kāi)口與鄰室相通的潔凈室,還應(yīng)測(cè)試開(kāi)口處的兩端壓差,氣流流速和氣流流型等。
①若使用指針型微壓差計(jì),則采用直接讀數(shù)法,并根據(jù)測(cè)試的壓差值評(píng)定該潔凈室(區(qū))與相鄰區(qū)域的氣體壓力,若使用其他微壓差計(jì),則應(yīng)先調(diào)整水平,確認(rèn)符合后方可進(jìn)行,若使用電子元件支持的數(shù)字式微壓差計(jì),則儀器開(kāi)機(jī)預(yù)熱至穩(wěn)定后,方可按說(shuō)明書(shū)的規(guī)定對(duì)儀器進(jìn)行校正,并選定相應(yīng)的測(cè)試量程范圍。
②若可能,宜將微壓差計(jì)的連接管盡量與采樣點(diǎn)水平面一致,采樣點(diǎn)位置離地約0.8m高度的水平面上,選擇在無(wú)渦流無(wú)回風(fēng)口的位置,在確認(rèn)讀數(shù)穩(wěn)定后可開(kāi)始測(cè)試。
③壓差值的采樣數(shù)據(jù)與標(biāo)準(zhǔn)比較得出合格與否的結(jié)論,測(cè)試壓差的同時(shí)應(yīng)結(jié)合被測(cè)潔凈室(區(qū))的換氣次數(shù)或截面風(fēng)速的測(cè)試,有利于對(duì)潔凈室(區(qū))進(jìn)行綜合評(píng)價(jià),A級(jí)(ISO Class5)以上潔凈級(jí)別的潔凈室(區(qū))在開(kāi)門(mén)時(shí),若必需,則要監(jiān)控門(mén)內(nèi)0.6m處的懸浮粒子的濃度。

(6)懸浮粒子的測(cè)試
采用計(jì)數(shù)濃度法,即通過(guò)測(cè)定潔凈環(huán)境內(nèi)單位體積空氣中含大于或等于某粒徑的懸浮粒子數(shù),來(lái)評(píng)定該潔凈室(區(qū))的潔凈度等級(jí)。測(cè)試方法采用ISO14644.1《Cleanrooms and asociated controlled environments-Part 1 Classification of air cleanliness》以及GB/T16292-2010《醫(yī)藥工業(yè)潔凈室(區(qū))懸浮粒子的測(cè)試方法》。為確認(rèn)A級(jí)潔凈區(qū)的級(jí)別,每個(gè)采樣點(diǎn)的采樣量不得少于1m3。A級(jí)潔凈區(qū)空氣懸浮粒子的級(jí)別為ISO4.8,以≥5.0um的懸浮粒子為限度標(biāo)準(zhǔn)。B級(jí)潔凈區(qū)(靜態(tài))的空氣懸浮粒子的級(jí)別為ISO5,同時(shí)包括表中兩種粒徑的懸浮粒子。對(duì)于C級(jí)潔凈區(qū)(靜態(tài)和動(dòng)態(tài))而言,空氣懸浮粒子的級(jí)別分別為ISO7和ISO8。對(duì)于D級(jí)潔凈區(qū)(靜態(tài))空氣懸浮粒子的級(jí)別為ISO8。
測(cè)試方法如下:①最少采樣點(diǎn)數(shù)量NL= 式中NL為最少采樣點(diǎn):A為潔凈室或被控潔凈區(qū)面積,m2
注:在水平單向流情況下,面積A為垂直于氣流方向的橫截面積。
靜態(tài)測(cè)試時(shí),采樣點(diǎn)離地面0.8m高度的水平面上均勻布置。每點(diǎn)采樣2~3次。

(7)浮游菌的測(cè)試
采用計(jì)數(shù)濃度法即通過(guò)收集懸游在空氣中的生物性粒子于專(zhuān)門(mén)的培養(yǎng)基,經(jīng)若干時(shí)間和適宜生長(zhǎng)條件讓其繁殖到可見(jiàn)的菌落計(jì)數(shù),以判斷該潔凈室的微生物濃度。
測(cè)試方法采用GB/T 16293-2010 醫(yī)藥工業(yè)潔凈室(區(qū))浮游菌的測(cè)試方法
1. 浮游菌測(cè)試的最少采樣點(diǎn)數(shù)目可參照GB/T 16292-2010 醫(yī)藥工業(yè)潔凈室(區(qū))懸浮粒子的測(cè)試方法。
2. 采樣點(diǎn)的位置
A) 工作區(qū)測(cè)點(diǎn)位置離地0.8m~1.5m左右(略高于工作面);
B) 送風(fēng)口測(cè)點(diǎn)位置離開(kāi)送風(fēng)面750px左右;
C) 可在關(guān)鍵設(shè)備或關(guān)鍵工作活動(dòng)范圍處增加測(cè)點(diǎn)。
3. 最小采樣量
浮游菌每次最小采樣量見(jiàn)表2。
表2

注:每個(gè)采樣點(diǎn)一般采樣一次。
4. 采樣注意事項(xiàng)
A) 對(duì)于單向流潔凈室(區(qū))或送風(fēng)口,采樣器采樣口朝向應(yīng)正對(duì)氣流方向;對(duì)于非單向流潔凈室(區(qū)),采樣口向上。
B) 布置采樣點(diǎn)時(shí),至少應(yīng)盡量避開(kāi)塵粒較集中的回風(fēng)口。
C) 采樣時(shí),測(cè)試人員應(yīng)站在采樣口的下風(fēng)側(cè),并盡量少走動(dòng)。
D) 應(yīng)采取一切措施防止采樣過(guò)程的污染和其他可能對(duì)樣本的污染。

(8) 沉降菌的測(cè)試
采用沉降法,即通過(guò)自然沉降原理收集空氣中的生物性粒子于培養(yǎng)皿,經(jīng)若干時(shí)間和適宜的生長(zhǎng)條件讓其繁殖到形成一個(gè)個(gè)獨(dú)立可見(jiàn)的菌落計(jì)數(shù)依據(jù),以判定該潔凈室(區(qū))的微生物濃度。
①沉降菌測(cè)試一般采用等規(guī)格的平板培養(yǎng)皿,也可根據(jù)工藝要求選擇合適的培養(yǎng)皿。
②培養(yǎng)基的準(zhǔn)備及滅菌、培養(yǎng)皿的制備、培養(yǎng)皿使用前的培養(yǎng)采用與本標(biāo)準(zhǔn)浮游菌測(cè)試相同的方法制備
③靜態(tài)測(cè)試時(shí)潔凈室(區(qū))沉降菌采樣點(diǎn)的布置應(yīng)遵循均勻全面的原則,避免采樣點(diǎn)在某局部區(qū)域過(guò)于集中,除非是為了特殊的目的。工作區(qū)采樣點(diǎn)位置離地0.8~1.5m左右,離開(kāi)送風(fēng)面750px以上,動(dòng)態(tài)測(cè)試時(shí)也可在關(guān)鍵設(shè)備或關(guān)鍵工序處增加采樣點(diǎn)。采樣點(diǎn)的位置可以與懸浮粒子的采樣點(diǎn)相同,每個(gè)采樣點(diǎn)至少采樣一次。
④對(duì)于單向流潔凈室(區(qū)),采樣時(shí)應(yīng)正對(duì)氣流方向,對(duì)于非單向流潔凈室(區(qū)),采樣時(shí)培養(yǎng)基平皿打開(kāi)向上,采樣時(shí)應(yīng)適當(dāng)避開(kāi)塵粒較集中的回風(fēng)口,測(cè)試人員在采樣時(shí)也應(yīng)站在采樣器管口的下風(fēng)側(cè)。
⑤在進(jìn)行測(cè)試之前,應(yīng)先對(duì)所用的培養(yǎng)皿進(jìn)行檢查,確認(rèn)沒(méi)有氣泡、無(wú)凹陷、無(wú)細(xì)菌生長(zhǎng)并在使用有效期內(nèi),培養(yǎng)皿在使用前必須用消毒劑擦凈外表面。
⑥采樣結(jié)束后,將培養(yǎng)皿倒置于恒溫培養(yǎng)箱中培養(yǎng)(35℃±2℃,48h)。
(9) 照度的測(cè)試
本標(biāo)準(zhǔn)定義的照度值為被測(cè)潔凈室(區(qū))的室內(nèi)最低照度值。采用直接讀書(shū)法,即通過(guò)測(cè)定潔凈環(huán)境內(nèi)各點(diǎn)的照度值,并從中篩選出最低照度值,從而評(píng)定該潔凈室(區(qū))的照度。
①照度測(cè)試應(yīng)在光源輸出趨于穩(wěn)定,并盡量避開(kāi)自然采光的情況下進(jìn)行,若有局部照明,則必須在測(cè)試記錄中注明動(dòng)態(tài)測(cè)試時(shí)的局部照明位置和局部照明的照度值,照度測(cè)試時(shí)應(yīng)確認(rèn)所以光源的工作狀態(tài)處于正常,否則必須詳細(xì)記錄光源狀況,應(yīng)注意測(cè)試者的投影以及服裝的反射影響測(cè)試結(jié)果。
②應(yīng)在測(cè)試出被測(cè)潔凈室(區(qū))的溫度值后再進(jìn)行照度測(cè)試。照度測(cè)試儀器開(kāi)機(jī)、預(yù)熱至穩(wěn)定后,方可按照說(shuō)明書(shū)的規(guī)定對(duì)儀器進(jìn)行校正,并選定相應(yīng)的測(cè)試量程范圍。
③應(yīng)將照度計(jì)的受光面盡量與測(cè)試點(diǎn)相應(yīng)水平面一致,在確認(rèn)讀數(shù)穩(wěn)定后方可開(kāi)始測(cè)試。
④照度測(cè)試的采樣點(diǎn)布置:任何潔凈室(區(qū))的采樣點(diǎn)不得少于2個(gè),除受潔凈室(區(qū))內(nèi)設(shè)備限值之外,采樣點(diǎn)應(yīng)再整個(gè)潔凈室(區(qū))內(nèi)均勻布置,采樣點(diǎn)距墻1m(小面積房間0.5m),按1~2m間距布點(diǎn)。每個(gè)選定的采樣點(diǎn)之間間距不超過(guò)2m,不刻意在燈下或避開(kāi)燈下選點(diǎn),至少采樣1次,在一個(gè)平面上,若以室內(nèi)工作臺(tái)為對(duì)象面時(shí),測(cè)試面定為其面上0.05m的水平面。

引用標(biāo)準(zhǔn)GB 50591-2010潔凈室施工及驗(yàn)收規(guī)范標(biāo)準(zhǔn)
(10)噪聲
一般情況下可只檢測(cè)A聲級(jí)的噪聲,必要時(shí)可采用帶倍頻程分析儀的聲級(jí)儀,按中心頻率63、125、250、500、1000、2000、4000、8000Hz的倍頻程檢測(cè),測(cè)點(diǎn)附近1m內(nèi)不應(yīng)有反射物。聲級(jí)計(jì)的最小刻度不宜低于0.2dB(A)。
測(cè)點(diǎn)距地面高度1.1m。面積在15m2以下的潔凈室,可只測(cè)室中心1點(diǎn),15m2以上的潔凈室除中心1點(diǎn)外,應(yīng)再測(cè)對(duì)角4點(diǎn),距側(cè)墻各1m,測(cè)點(diǎn)朝向各角。
當(dāng)為混合流潔凈室時(shí),應(yīng)分別測(cè)定單向流區(qū)域、非單向流區(qū)域的噪聲。
有條件是,宜測(cè)定空調(diào)凈化系統(tǒng)停止運(yùn)行后的本底噪聲,室內(nèi)噪聲與本底噪聲相差小于10dB(A)時(shí),應(yīng)對(duì)測(cè)點(diǎn)值進(jìn)行修正:相差(6~9)dB(A)時(shí)減1dB(A),相差(4~5)dB(A)

(11)高效過(guò)濾器檢漏光度計(jì)法
1被檢漏過(guò)濾器必須已測(cè)過(guò)風(fēng)量,在設(shè)計(jì)風(fēng)速的80%~120%之間運(yùn)行。
2在同一送風(fēng)面上按有多臺(tái)過(guò)濾器時(shí),在結(jié)構(gòu)上允許的情況下,宜用每次只暴露1臺(tái)過(guò)濾器的方法進(jìn)行測(cè)定。
3當(dāng)幾臺(tái)或全部過(guò)濾器必須同時(shí)暴露在氣溶膠中時(shí),為了對(duì)所有過(guò)濾器造成均勻混合,宜在風(fēng)機(jī)吸入端或這些過(guò)濾器前方支干管中引入檢漏有氣溶膠,并立即在受檢過(guò)濾器的正前方測(cè)定上風(fēng)側(cè)濃度。
4對(duì)于高校過(guò)濾器,當(dāng)檢漏儀表為對(duì)數(shù)刻度是,上風(fēng)側(cè)氣溶膠濃度應(yīng)超過(guò)儀表最小刻度的104倍。當(dāng)檢漏儀表為線性刻度時(shí),上風(fēng)側(cè)氣溶膠濃度宜達(dá)到(20~80)μg/L,濃度低于20μg/L會(huì)降低檢漏靈敏度,高于80μg/L長(zhǎng)時(shí)間檢測(cè)會(huì)造成過(guò)濾器污染堵塞。檢漏儀表應(yīng)具有(0.001~100)μg/L的測(cè)量范圍。
5對(duì)于光度計(jì)檢漏法確認(rèn)過(guò)濾器局部滲漏的標(biāo)準(zhǔn)透過(guò)率為0.01%,即當(dāng)采樣探頭對(duì)準(zhǔn)被測(cè)過(guò)濾器的出風(fēng)某一點(diǎn),靜止檢測(cè)時(shí),如測(cè)得透過(guò)率高于0.01%,即認(rèn)為該點(diǎn)為漏點(diǎn)。
時(shí)減2dB(A),相差3dB(A)時(shí)減3dB(A),相差小于3dB(A)時(shí)測(cè)定值無(wú)效。

